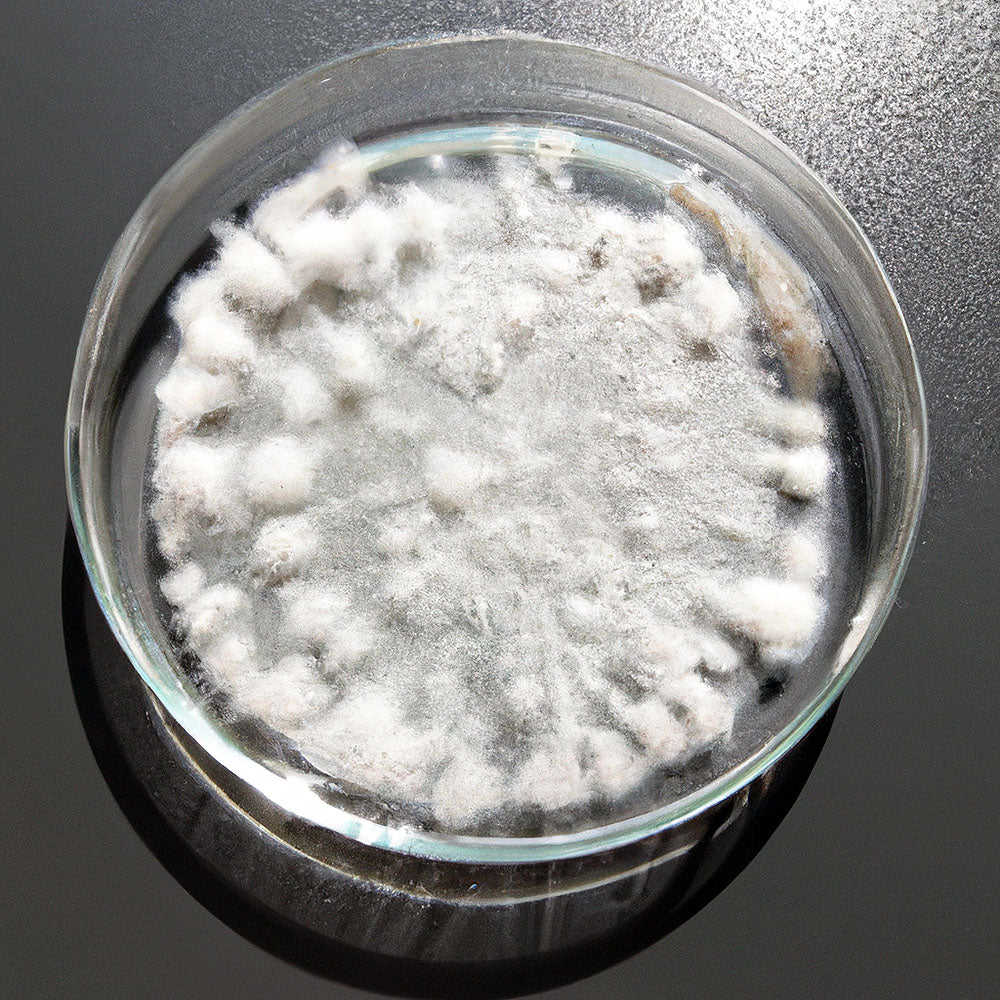

Description
- 10cc liquid culture of Cordyceps Sinensis CS4 Genetic Isolate
- Perfect for inoculating sterilized grain substrates and malt extract agar
- Efficient mycelium propagation for both beginner and advanced cultivators
- Unique mushroom strain for medicinal and research applications
- Optimized for mycelium storage and long-term viability
- Naturally found in high-altitude regions and on specific caterpillars
- Renowned for its traditional medicinal uses, especially in Traditional Chinese Medicine
- Ensure proper cultivation environment for optimal growth and yield
Cordyceps Sinensis CS4 Genetic Isolate: A Gem in Mushroom Cultivation
Introduction
Our Cordyceps Sinensis CS4 Genetic Isolate liquid culture offers the keen mycologist an unparalleled opportunity to delve deep into the world of mushroom cultivation. With this 10cc liquid culture syringe, you are not just purchasing a product; you are embarking on a journey through the mesmerizing lifecycle of one of the world's most coveted fungi.
A Glimpse Into Its Habitat
Originating from the high-altitude regions of the Himalayas, Cordyceps Sinensis thrives in the wild by infecting and growing on specific caterpillar hosts. This parasitic relationship is an extraordinary testament to the adaptability and resilience of this mushroom species.
Cultivation Specifics
While the natural life cycle of Cordyceps Sinensis is intriguing, cultivating it requires expertise. It thrives best when inoculated on sterilized grain substrates or malt extract agar. While beginner mushroom cultivation can achieve success with this strain, advanced mushroom cultivation techniques often result in superior yields. Ensuring a proper mushroom cultivation environment with optimal temperature and humidity levels is vital. Challenges might arise, but with our extensive mycology and cultivation resources, we've got you covered.
Medicinal and Research Significance
This particular strain isn't typically grown for culinary delights; its value lies in its potential medicinal properties. Traditionally cherished in Traditional Chinese Medicine, Cordyceps Sinensis has been researched for various health benefits. However, always remember to consult with a healthcare professional before consuming any mushroom product for medicinal purposes.
Storage and Expansion
Mycelium storage best practices involve keeping the liquid culture in a cool, dark place. When you're ready, expanding mushroom cultures from this syringe is straightforward. With the right mushroom cultivation equipment and a sterile environment, you can propagate the mycelium and venture into sustainable mushroom farming at home.
Whether you're gearing up for DIY mushroom cultivation setups or simply wish to add this to your collection of mushroom strains and cultures, this liquid culture is a must-have.
Disclaimer: Consuming mushrooms can be dangerous. Misidentification or consumption of poisonous mushrooms can cause serious illness or death. This product is not intended to diagnose, treat, cure, or prevent any disease. Always consult with an expert before consuming any mushroom.
Ready to explore the intriguing world of Cordyceps Sinensis CS4 Genetic Isolate? Dive in and let the cultivation journey begin!
Related Resources
Cordyceps Sinensis CS4 Liquid Culture Syringe
We have run out of stock for this item.
Description
- 10cc liquid culture of Cordyceps Sinensis CS4 Genetic Isolate
- Perfect for inoculating sterilized grain substrates and malt extract agar
- Efficient mycelium propagation for both beginner and advanced cultivators
- Unique mushroom strain for medicinal and research applications
- Optimized for mycelium storage and long-term viability
- Naturally found in high-altitude regions and on specific caterpillars
- Renowned for its traditional medicinal uses, especially in Traditional Chinese Medicine
- Ensure proper cultivation environment for optimal growth and yield
Cordyceps Sinensis CS4 Genetic Isolate: A Gem in Mushroom Cultivation
Introduction
Our Cordyceps Sinensis CS4 Genetic Isolate liquid culture offers the keen mycologist an unparalleled opportunity to delve deep into the world of mushroom cultivation. With this 10cc liquid culture syringe, you are not just purchasing a product; you are embarking on a journey through the mesmerizing lifecycle of one of the world's most coveted fungi.
A Glimpse Into Its Habitat
Originating from the high-altitude regions of the Himalayas, Cordyceps Sinensis thrives in the wild by infecting and growing on specific caterpillar hosts. This parasitic relationship is an extraordinary testament to the adaptability and resilience of this mushroom species.
Cultivation Specifics
While the natural life cycle of Cordyceps Sinensis is intriguing, cultivating it requires expertise. It thrives best when inoculated on sterilized grain substrates or malt extract agar. While beginner mushroom cultivation can achieve success with this strain, advanced mushroom cultivation techniques often result in superior yields. Ensuring a proper mushroom cultivation environment with optimal temperature and humidity levels is vital. Challenges might arise, but with our extensive mycology and cultivation resources, we've got you covered.
Medicinal and Research Significance
This particular strain isn't typically grown for culinary delights; its value lies in its potential medicinal properties. Traditionally cherished in Traditional Chinese Medicine, Cordyceps Sinensis has been researched for various health benefits. However, always remember to consult with a healthcare professional before consuming any mushroom product for medicinal purposes.
Storage and Expansion
Mycelium storage best practices involve keeping the liquid culture in a cool, dark place. When you're ready, expanding mushroom cultures from this syringe is straightforward. With the right mushroom cultivation equipment and a sterile environment, you can propagate the mycelium and venture into sustainable mushroom farming at home.
Whether you're gearing up for DIY mushroom cultivation setups or simply wish to add this to your collection of mushroom strains and cultures, this liquid culture is a must-have.
Disclaimer: Consuming mushrooms can be dangerous. Misidentification or consumption of poisonous mushrooms can cause serious illness or death. This product is not intended to diagnose, treat, cure, or prevent any disease. Always consult with an expert before consuming any mushroom.
Ready to explore the intriguing world of Cordyceps Sinensis CS4 Genetic Isolate? Dive in and let the cultivation journey begin!